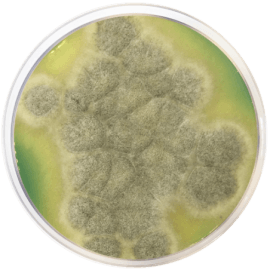
main product photo

Close
m-Green agar fungi and yeast 500 grams/bottle
SKU
CDL/2108
Brand
CONDALAB
Pre-order (Deliver in 8 to 12 weeks)
M-Green Agar for Fungi and Yeasts is a medium used for the detection of yeast and fungi in beverages. This formulation is rich in nutrients which allows for excellent fungal growth.
Casein and gelatin peptone provides nitrogen, vitamins, minerals and amino acids essential for growth. Yeast extract is a source of vitamins, particularly of the B-group. Dextrose is the fermentable carbohydrate providing carbon and energy. Bacteriological agar is the solidifying agent. Potassium phosphate is a buffering agent. Magnesium sulfate, thiamine, and diastase (a mixture containing amylolytic (starch) enzymes) provide essential ions, minerals, and nutrients. Bromcresol Green is the pH indicator, facilitating visualization and counting of fungal colonies. The colonies are green due to diffusion of bromcresol green into the colonies. The end products of the microbial growth diffuse into the medium, reducing the pH and turn the indicator to yellow. Bacterial growth is inhibited by an acid pH.
Yeast are large green opaque colonies. Mould appear green and filamentous. Bacteria able to grow at this pH form smaller clear to white colonies.
M-Green Agar for Fungi and Yeasts is a medium used for the detection of yeast and fungi in beverages. This formulation is rich in nutrients which allows for excellent fungal growth.
Casein and gelatin peptone provides nitrogen, vitamins, minerals and amino acids essential for growth. Yeast extract is a source of vitamins, particularly of the B-group. Dextrose is the fermentable carbohydrate providing carbon and energy. Bacteriological agar is the solidifying agent. Potassium phosphate is a buffering agent. Magnesium sulfate, thiamine, and diastase (a mixture containing amylolytic (starch) enzymes) provide essential ions, minerals, and nutrients. Bromcresol Green is the pH indicator, facilitating visualization and counting of fungal colonies. The colonies are green due to diffusion of bromcresol green into the colonies. The end products of the microbial growth diffuse into the medium, reducing the pH and turn the indicator to yellow. Bacterial growth is inhibited by an acid pH.
Yeast are large green opaque colonies. Mould appear green and filamentous. Bacteria able to grow at this pH form smaller clear to white colonies.
| Brand | CONDALAB |
|---|
Write Your Own Review

Validate your login